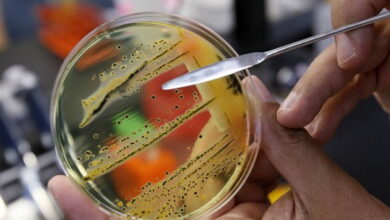
Сальмонела та ботулізм

День: 10.06.2024
-
Происшествия
%22%20transform%3D%22translate(.8%20.8)%20scale(1.52344)%22%20fill-opacity%3D%22.5%22%3E%3Cellipse%20fill%3D%22%23001%22%20rx%3D%221%22%20ry%3D%221%22%20transform%3D%22rotate(18.7%20-335%20241.7)%20scale(86.25333%2049.33256)%22%2F%3E%3Cellipse%20fill%3D%22%23f5a71d%22%20rx%3D%221%22%20ry%3D%221%22%20transform%3D%22matrix(13.1136%20-53.389%20153.76233%2037.76765%20211.7%2034.2)%22%2F%3E%3Cellipse%20fill%3D%22%23ff9640%22%20rx%3D%221%22%20ry%3D%221%22%20transform%3D%22matrix(28.7248%2037.1062%20-23.44239%2018.14731%20234%2023)%22%2F%3E%3Cellipse%20fill%3D%22%23001627%22%20cx%3D%2261%22%20cy%3D%22132%22%20rx%3D%2247%22%20ry%3D%2247%22%2F%3E%3C%2Fg%3E%3C%2Fsvg%3E)
Директор и инженер в Николаеве присвоили более полумиллиона гривен бюджетных средств
Департамент Николаевского городского совета заключил договор со строительным предприятием на реконструкцию и термомодернизацию здания детского сада. Директор подрядного предприятия, с намерением присвоить…
-
Общество
%27%20fill-opacity%3D%27.5%27%3E%3Cellipse%20fill%3D%22%23bd5936%22%20fill-opacity%3D%22.5%22%20rx%3D%221%22%20ry%3D%221%22%20transform%3D%22matrix(-39.51964%20-10.36778%2028.35365%20-108.07768%20215.7%2043.8)%22%2F%3E%3Cpath%20fill%3D%22%236f6b75%22%20fill-opacity%3D%22.5%22%20d%3D%22M23.6%20130.3l157-154%2010.6%20178.3z%22%2F%3E%3Cellipse%20fill%3D%22%236e7076%22%20fill-opacity%3D%22.5%22%20rx%3D%221%22%20ry%3D%221%22%20transform%3D%22matrix(-41.585%20-127.9855%2037.213%20-12.09124%20280.2%20200.6)%22%2F%3E%3Cellipse%20fill%3D%22%232f3537%22%20fill-opacity%3D%22.5%22%20rx%3D%221%22%20ry%3D%221%22%20transform%3D%22matrix(55.8521%20172.20233%20-81.38921%2026.39778%20361.8%2068.4)%22%2F%3E%3C%2Fg%3E%3C%2Fsvg%3E)
Без воды больше, чем трое суток: жители Корабельного района страдают из-за аварии
8 июня 2024 года "Николаевводоканал" сообщил, что из-за аварийных работ на ул. Новозаводской, 1а, 1б было прекращено водоснабжение в микрорайоне Кульбакино, расположенном…
-
Происшествия
%22%20transform%3D%22translate(.8%20.8)%20scale(1.52344)%22%20fill-opacity%3D%22.5%22%3E%3Cellipse%20fill%3D%22%23c6c4c5%22%20rx%3D%221%22%20ry%3D%221%22%20transform%3D%22rotate(86.8%2088.6%20106.6)%20scale(31.31844%2075.75498)%22%2F%3E%3Cellipse%20fill%3D%22%230f0d0e%22%20rx%3D%221%22%20ry%3D%221%22%20transform%3D%22matrix(-2.84%2036.43482%20-175.6031%20-13.68782%20107.3%2085)%22%2F%3E%3Cellipse%20fill%3D%22%23839790%22%20cx%3D%2289%22%20cy%3D%221%22%20rx%3D%22174%22%20ry%3D%2218%22%2F%3E%3Cellipse%20fill%3D%22%23595858%22%20cx%3D%22203%22%20cy%3D%2245%22%20rx%3D%22100%22%20ry%3D%2222%22%2F%3E%3C%2Fg%3E%3C%2Fsvg%3E)
Смертельное ДТП на Николаевщине: столкнулись Opel и микроавтобус, погиб один человек
В результате лобового столкновения легкового автомобиля Opel Astra и микроавтобуса FORD от полученных травм погиб водитель первого 1947 г. р. Аварийно-спасательное отделение…
-
Происшествия
%22%20transform%3D%22translate(.8%20.8)%20scale(1.52344)%22%20fill-opacity%3D%22.5%22%3E%3Cellipse%20fill%3D%22%235c5c5c%22%20rx%3D%221%22%20ry%3D%221%22%20transform%3D%22rotate(-10.7%20552.3%20-22.5)%20scale(44.39894%20215.53748)%22%2F%3E%3Cellipse%20fill%3D%22%23535353%22%20rx%3D%221%22%20ry%3D%221%22%20transform%3D%22rotate(29.3%20-211%20231.2)%20scale(33.58145%2017.66065)%22%2F%3E%3Cellipse%20fill%3D%22%237a7a7a%22%20cy%3D%2211%22%20rx%3D%2225%22%20ry%3D%2225%22%2F%3E%3Cellipse%20fill%3D%22%23181818%22%20cx%3D%22167%22%20cy%3D%2237%22%20rx%3D%22110%22%20ry%3D%22110%22%2F%3E%3C%2Fg%3E%3C%2Fsvg%3E)
Шокирующая драка на Намыве: мужчина ударил беременную женщину, полиция вмешалась
Очевидцы утверждают, что драка началась из-за того, что мужчина ударил беременную женщину. Возмущенные свидетели решили "поговорить" с агрессором, что и привело к…
-
Общество
%27%20fill-opacity%3D%27.5%27%3E%3Cellipse%20fill%3D%22%23541403%22%20fill-opacity%3D%22.5%22%20rx%3D%221%22%20ry%3D%221%22%20transform%3D%22matrix(-10.40543%20-52.07411%20103.21389%20-20.62417%2057%2026.7)%22%2F%3E%3Cellipse%20fill%3D%22%23672b02%22%20fill-opacity%3D%22.5%22%20rx%3D%221%22%20ry%3D%221%22%20transform%3D%22rotate(-171.9%20188.6%205)%20scale(163.00133%2045.77307)%22%2F%3E%3Cellipse%20fill%3D%22%23e3a9b4%22%20fill-opacity%3D%22.5%22%20rx%3D%221%22%20ry%3D%221%22%20transform%3D%22matrix(3.5538%20101.7676%20-214.38655%207.48654%20168.9%20207.7)%22%2F%3E%3Cellipse%20fill%3D%22%23c28c37%22%20fill-opacity%3D%22.5%22%20rx%3D%221%22%20ry%3D%221%22%20transform%3D%22rotate(-40.1%20394.6%20-398.2)%20scale(75.01568%20112.50932)%22%2F%3E%3C%2Fg%3E%3C%2Fsvg%3E)
Из Корабельного района на пьедестал: Алиса Иванова одержала победу в латинском соло
Состоялся турнир по танцевальному спорту под названием "Южная столица". Алиса Андреевна, жительница Корабельного района, завоевала золото в категории соло ювеналов в открытом…
-
Общество
%22%20transform%3D%22translate(.8%20.8)%20scale(1.52344)%22%20fill-opacity%3D%22.5%22%3E%3Cellipse%20fill%3D%22%23ef962f%22%20rx%3D%221%22%20ry%3D%221%22%20transform%3D%22matrix(30.61645%20.8918%20-1.77977%2061.10196%20121.8%2090.9)%22%2F%3E%3Cellipse%20fill%3D%22%236c7833%22%20cx%3D%2270%22%20cy%3D%22111%22%20rx%3D%2229%22%20ry%3D%2254%22%2F%3E%3Cellipse%20fill%3D%22%23a9c075%22%20cx%3D%22210%22%20cy%3D%22101%22%20rx%3D%2268%22%20ry%3D%2268%22%2F%3E%3Cellipse%20fill%3D%22%236b6b73%22%20rx%3D%221%22%20ry%3D%221%22%20transform%3D%22matrix(-164.5167%20-4.89209%201.08214%20-36.39136%2096.3%200)%22%2F%3E%3C%2Fg%3E%3C%2Fsvg%3E)
Футболист из Николаева Сергей Баев получил серебро на Европейском чемпионате в составе дефлимпийской сборной
Присоединяемся к поздравлениям нашей национальной команды с таким высоким достижением и желаем дальнейших побед! ?
-
Происшествия
%22%20transform%3D%22translate(.8%20.8)%20scale(1.52344)%22%20fill-opacity%3D%22.5%22%3E%3Cellipse%20fill%3D%22%23101328%22%20rx%3D%221%22%20ry%3D%221%22%20transform%3D%22matrix(40.14299%20-77.9058%2047.03598%2024.23651%20242.3%2077.4)%22%2F%3E%3Cellipse%20fill%3D%22%23c26d20%22%20cx%3D%22120%22%20cy%3D%22128%22%20rx%3D%2258%22%20ry%3D%2297%22%2F%3E%3Cellipse%20fill%3D%22%23a3b6c2%22%20rx%3D%221%22%20ry%3D%221%22%20transform%3D%22matrix(9.4199%20-25.72996%2035.73649%2013.08336%2024%20125.2)%22%2F%3E%3Cellipse%20fill%3D%22%23a4a68b%22%20rx%3D%221%22%20ry%3D%221%22%20transform%3D%22matrix(-33.31045%20-38.18448%2026.5191%20-23.1341%20104.4%2012.8)%22%2F%3E%3C%2Fg%3E%3C%2Fsvg%3E)
Пищевые отравления в Николаеве: три угрозы жизни, пострадало 7 человек, у двоих - ботулизм
? В течение первых пяти месяцев 2024 года в Николаеве зарегистрировано три угрозы жизни и здоровью из-за инфекционных болезней и пищевых отравлений.
-
Политика
%22%20transform%3D%22translate(.8%20.8)%20scale(1.52344)%22%20fill-opacity%3D%22.5%22%3E%3Cellipse%20fill%3D%22%231c3b4d%22%20cx%3D%22141%22%20cy%3D%22108%22%20rx%3D%2275%22%20ry%3D%2275%22%2F%3E%3Cellipse%20fill%3D%22%238f4c0c%22%20rx%3D%221%22%20ry%3D%221%22%20transform%3D%22rotate(88.5%2051%2071.2)%20scale(33.05361%20166.1627)%22%2F%3E%3Cellipse%20fill%3D%22%23240800%22%20cx%3D%22213%22%20cy%3D%22109%22%20rx%3D%2262%22%20ry%3D%2258%22%2F%3E%3Cellipse%20fill%3D%22%2383745d%22%20cx%3D%22132%22%20cy%3D%221%22%20rx%3D%2228%22%20ry%3D%2263%22%2F%3E%3C%2Fg%3E%3C%2Fsvg%3E)
Электронные сообщения через кабинеты не будут - Федор Вениславский
Прошло уже более трех недель с момента, когда начал действовать новый закон о мобилизации. Согласно этим изменениям, мужчины в возрасте от 18…
-
Политика
%22%20transform%3D%22translate(.8%20.8)%20scale(1.52344)%22%20fill-opacity%3D%22.5%22%3E%3Cellipse%20fill%3D%22%23bf7221%22%20rx%3D%221%22%20ry%3D%221%22%20transform%3D%22matrix(207.52147%2018.0237%20-2.56022%2029.47785%2081.2%20124.7)%22%2F%3E%3Cellipse%20fill%3D%22%237b8899%22%20rx%3D%221%22%20ry%3D%221%22%20transform%3D%22matrix(-3.2994%2031.75589%20-247.09047%20-25.67237%20140.4%2055.6)%22%2F%3E%3Cellipse%20fill%3D%22%234e4f28%22%20rx%3D%221%22%20ry%3D%221%22%20transform%3D%22matrix(2.36354%20-17.25425%2071.48258%209.7919%2089.4%2096.5)%22%2F%3E%3Cellipse%20fill%3D%22%23424e5e%22%20cx%3D%22179%22%20rx%3D%22162%22%20ry%3D%2227%22%2F%3E%3C%2Fg%3E%3C%2Fsvg%3E)
Скандал во власти: Мустафа Найем, глава Агентства восстановления, уходит в отставку из-за препятствий
? Отставка главы Агентства восстановления стала сенсацией! В своем заявлении он раскрыл системные препятствия и бюрократическое давление, которые не позволяли работать эффективно.…